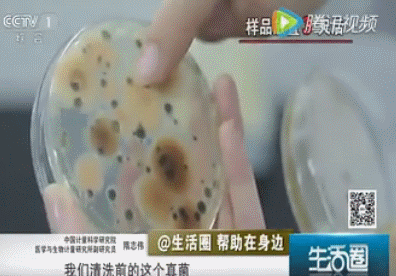

- +1
吹空调=吹细菌?空调竟比马桶还脏?
原创 酸菜 医学界呼吸频道

夏天马(yi)上(jing)到了,
默默开启尘封已久的空调……




家里的空调就没有清洗过……
空调到底有多脏?
直接上图!



事实上,长期未清洗的空调存在很多微生物、粉尘、细菌、真菌等,开启时若不进行清洗很容易引起呼吸道感染。
早在2004年底卫生部就在全国60多个城市,对近千家宾馆、商场等公共场所的集中空调进行抽检,结果显示卫生合格率只有6%。其中风管污染是最主要原因,抽检的近千家宾馆中,风管积尘超标最严重的高达476倍。
风管污染产生原因:
空气中各类悬浮物不能完全被中央空调过滤装置所阻隔,中央空调所使用的粗效过滤器只能阻隔40%的可悬浮颗粒物,部分灰尘颗粒进入管道堆积;
微细颗粒与风道内壁产生静电吸附,灰尘也就越积越厚;
堆积的灰尘极易滋生各类微生物,如:病毒、细菌、军团菌、冠状病毒等;
风道内部温、湿度适宜于各种病菌和昆虫滋生并寄生于其中,甚至有老鼠及蟑螂存在。
2006年,卫生部对全国集中空调的抽检结果也印证了这个问题。检测发现由于风管污染的原因,空调所送空气的卫生质量问题最为严重,细菌总数全国平均超标36.9%,可吸入颗粒物超标29.6%。
2008年,有研究者对深圳、北京地区家用空调进行微生物污染问题及其消毒效果的调查。
并不意外的发现,深圳地区细菌及真菌总数的平均值分别为891.96 cfu/cm2,799.86 cfu/cm2,北京地区细菌及真菌总数的平均值分别为3866.48 cfu/cm2,127.83 cfu/cm2,报告的数据均超过2012年《公共场所集中空调通风系统卫生规范》规定细菌总数和真菌总数菌落数应≤100 cfu/cm2。

将许久未清洁的空调打开,在空调房内放上两份米饭,一份米饭敞开盒盖,一份米饭盖上饭盒盖,但是并非完全密闭,米饭处于半密封状态。等待72小时以后,来揭晓实验结果。

其中,军团菌是潜藏在集中空调里最致命的杀手。如果集中空调受到军团菌的污染,人们很容易感染军团菌病。
上海空调清洗行业协会副秘书长王彬在接受新民晚报采访表示,中央空调开之前最好先“洗个澡”。目前本市公共场所基本实现集中空调定期清洗消毒全覆盖,但商务楼宇方面还没能引起足够重视。
“据不完全统计,商务写字楼集中空调的定期清洗率仅为20%-30%,大量集中空调长期未进行清洗。”
有研究者对北京市14家大饭店(四五星级)中央空调38个冷却塔进行军团病的病原学检测,结果显示所调查的饭店中12家空调冷却塔有军团菌污染,污染率达85.7%,有21个冷却塔检出军团菌,阳性率为55.3%(21/38),共分离16株军团菌,均为嗜肺军团菌种。
军团菌常伴随空调制冷装置中随冷风吹出,该病尤其易发生在配备有密闭式中央空调的办公环境里,感染者出现上呼吸道感染及发热的症状,严重者可导致呼吸衰竭和肾衰竭。
杭州市第一人民医院呼吸内科副主任沈凌医生告诉“医学界”:
“
军团菌的确是夏天多见,与使用空调有一定关系,但由于大多数医院缺少诊断手段,所以基本上根据临床判断的。患者主要特点是高热、干咳无痰、肺外症状明显(腹泻、低钠血症),通常C反应蛋白增高明显,以及肌酸激酶增高明显。
”
军团菌病主要的感染途径是人吸入被污染的气溶胶。
气溶胶来源包括空调冷却塔、冷热水系统、加湿器、温泉等。
军团菌病发病的季节分布、年龄分布和性别分布特征各地基本一致。6-10月为高发季节,发病高峰为8-9月;在已报告的病例中,在年龄分布上,老年人发病多,男性多于女性。
怎样预防呢?
1、加强水资源管理及人工输水管道和设施的消毒处理,防止军团菌造成空气和水源污染,这是预防军团菌病扩散的重要措施;
2、医院、办公楼、商场、机场、地铁站等大型建筑物,要对中央空调系统,冷却塔等设备进行定期检测,保持这些设备冷热水系统的清洁;
3、对自己家里的空调,浴室里的淋浴器等设备也要进行定期检测,消毒,保持其卫生清洁。李涛等人的研究调查显示,家用空调经过消毒后,细菌总数及真菌总数杀灭率均超过95%。
复旦大学附属中山医院呼吸科张新教授也再次强调:
“
对空调,特别是中央空调系统要清理打扫,尽量让空调冷凝液少积聚;汽车玻璃水要用不利于细菌繁殖的液体,比如用含清洁剂的,不要直接用清水;对非典型肺炎的患者要注意军团菌肺炎的诊断性检测,以免延误病情、产生严重后果。
”
小编还要再啰嗦一句,在空调清洁过程中还得注意戴口罩哦。







[1] 彭晓旻,裴红生,黎新宇, 等.北京市大饭店空调冷却塔军团菌污染现况及人群感染水平研究[J].中华流行病学杂志,2000,21(4):289-291. DOI:10.3760/j.issn:0254-6450.2000.04.014.
[2] 李涛,周铁生,李睿, 等.家用空调微生物污染问题及其消毒效果的研究[J].中国预防医学杂志,2010,11(1):66-69.
[3]空调不清洁=直接吃毒!央视记者亲身揭秘空调到底有多脏!-微信公众号:乐活记
本文来源:医学界呼吸频道
本文作者:酸菜
责任编辑:施小雅
版权申明
本文原创 转载请联系授权
- End -
本文为澎湃号作者或机构在澎湃新闻上传并发布,仅代表该作者或机构观点,不代表澎湃新闻的观点或立场,澎湃新闻仅提供信息发布平台。申请澎湃号请用电脑访问http://renzheng.thepaper.cn。





- 报料热线: 021-962866
- 报料邮箱: news@thepaper.cn
互联网新闻信息服务许可证:31120170006
增值电信业务经营许可证:沪B2-2017116
© 2014-2026 上海东方报业有限公司




